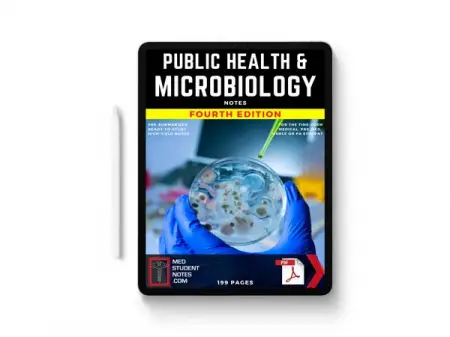
MEDSTUDENTNOTES.COM
Lifetime Access
Shop Now

MEDSTUDENTNOTES.COM
Lifetime Access
Shop Now
Some descriptions are auto translated, meaning might have changed a little or a lot.

Email:
Contact Number:
Age: 32 (report if not 18+)
REPORT
Post your own ad > get emails > Select one > Start dating.
*You must be 18+.
POST AD NOW
BackpageAfrica.com is a Backpage Equivalent african website with a good control at user level, community level. BackpageAfrica.com is a classified web app like a regular classified website. It is similar to craigslist personals, gumtree, backpage, bedpage for personal ads.
Disclaimer: Please ignore under 18 users, we highly discourage them. Any ad misleading, prone to human traffiking, outlawed, scamming will be removed without prior notice.
Cheating Alert! Cheating is everywhere, stay cautious. Any advertise if asks for up front, gifts, any login data or any means of payment may be somebody behind a scam and use your brain to avoid such a trap. Backpage Africa does not encourage scam party, cheating people.
Copyright: Backpage Africa (c) 2025 | Privacy Policy | Contact Us